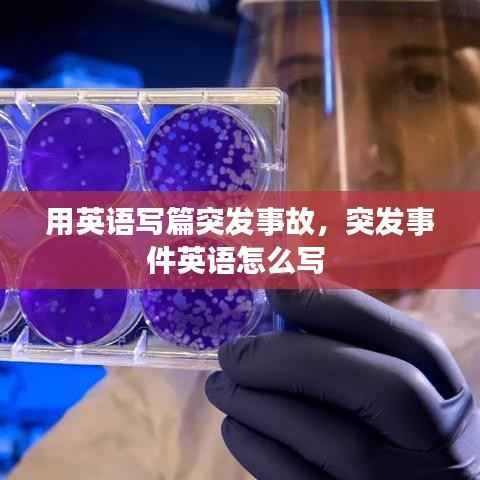
用英语写篇突发事故，突发事件英语怎么写

Introduction
On a sunny afternoon, the bustling city of New York was caught off guard by a sudden and unexpected accident that would leave many people in shock and disbelief. The streets were filled with the sounds of honking cars and the chaotic chatter of pedestrians, all of whom were trying to make sense of the unfolding disaster.
The Incident
The accident began when a large truck, carrying a cargo of chemicals, lost control while navigating through the busy streets. The driver, who was inexperienced and overconfident, attempted a risky maneuver to avoid a collision with another vehicle, but it backfired spectacularly. The truck veered off the road, crashing into a nearby building and causing a massive explosion.
The Explosion
The explosion was so powerful that it shattered windows in buildings several blocks away. Debris and smoke billowed into the air, creating a thick, acrid cloud that blocked out the sun. Emergency services were immediately dispatched to the scene, but the situation was quickly escalating out of control. Firefighters worked tirelessly to extinguish the flames, while paramedics treated the injured and searched for survivors.
The Casualties
The initial reports indicated that the explosion had caused significant damage to the surrounding area. Several buildings were destroyed, and many more were severely damaged. The toll of the accident was devastating, with reports of multiple fatalities and countless injuries. Among the victims were innocent bystanders, emergency responders, and even the driver of the truck, who was killed in the crash.
The Response
The city's response to the disaster was swift and coordinated. Authorities worked around the clock to assess the damage, provide aid to the injured, and ensure the safety of the public. Law enforcement officials cordoned off the area to prevent further chaos and to allow emergency personnel to do their work. Volunteers and community organizations also stepped in to offer support and comfort to those affected by the tragedy.
The Investigation
As the dust settled and the emergency response came to an end, authorities began the process of investigating the cause of the accident. They focused on several key factors, including the truck's mechanical condition, the driver's qualifications, and the road conditions at the time of the incident. The investigation revealed that the truck's brakes had failed, and the driver had been under the influence of alcohol, contributing to the tragic outcome.
The Aftermath
The aftermath of the accident was a period of grief and recovery for the city of New York. Families mourned their loved ones, and survivors grappled with the physical and emotional scars of the disaster. The community came together to support each other, organizing fundraisers and support groups to help those affected. In the wake of the tragedy, there was a renewed call for stricter regulations on trucking companies and a greater emphasis on driver safety training.
The Lessons Learned
The accident served as a stark reminder of the potential dangers associated with heavy machinery and the importance of safety protocols. It also highlighted the resilience and strength of the human spirit in the face of adversity. The city of New York, while still reeling from the loss, learned valuable lessons that would help prevent similar incidents in the future. The incident sparked a national conversation about transportation safety and the need for stricter regulations to protect both the public and the workers in the industry.
Conclusion
The sudden and devastating accident in New York City was a tragic event that left an indelible mark on the community. It served as a powerful reminder of the fragility of life and the importance of safety. While the pain of the loss will never fully heal, the memory of the event will continue to inspire change and vigilance in the years to come. The city of New York, with its resilience and determination, will undoubtedly rise from this tragedy stronger and more prepared to face the challenges of the future.
转载请注明来自南京强彩光电科技有限公司,本文标题:《用英语写篇突发事故,突发事件英语怎么写 》

苏ICP备18007744号-2
苏ICP备18007744号-2
还没有评论,来说两句吧...